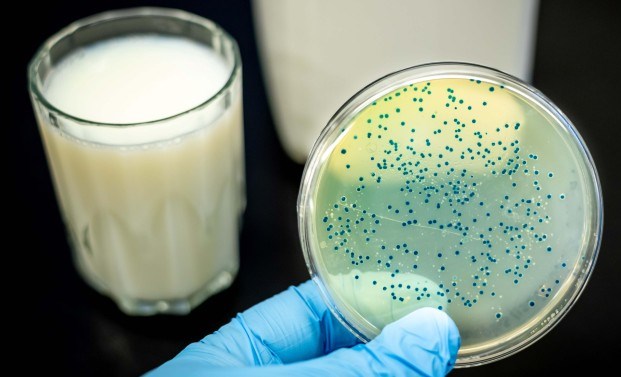

1. Etken nedir? Nasıl bir bakteridir?
Etkeni Brucella spp’dir. Bakteri 0.6-1.5 µm boyunda, küçük, gram negatif, hareketsiz, sporsuz, aerop veya mikroaerofil olup kokobasil özelliğindedir. İntrasellüler üreyen bir bakteridir. İdeal üreme ısısı 37°C’dir, ancak 20-40°C’de de üreyebilmektedir. B. melitensis (koyun, keçi); B. abortus (inek, deve); B. suis (domuz); B.canis (köpek) serotipleri mevcuttur. B. melitensis dünya genelinde en yaygın görülen, en virülan türdür.
Bruselloz; Malta humması, Akdeniz dalgalı humması, Cebelitarık kayalık humması, Girit humması, dalgalı humma, ondülan ateş, peynir hastalığı, mal hastalığı ve koyun hastalığı adları ile de bilinmektedir. Dünyadaki en yaygın zoonozlardan biridir. Her yıl yaklaşık 500.000 yeni olgu bildirilmektedir
2. Bulaş yolları nelerdir?
Sığır, koyun, keçi gibi enfekte hayvanların doku/vücut sıvıları ile temas yoluyla veya ürünlerinin tüketilmesi ile insana bulaşan bir zoonotik hastalıktır.
Kaynatılmadan hazırlanan süt ve süt ürünlerinin tüketilmesi en önemli bulaş yoludur. Enfekte hayvanların eti, sütü, salyaları, idrarı, dışkısı, atık yavruları ile temas sonucu bulaşabilmektedir. İnhalasyon ile bulaşmada mümkündür. İnsandan insana bulaş nadirdir. Ancak transplasental, emzirme, transfüzyon ve cinsel yolla bildirilen olgular literatürde bulunmaktadır.
Multisistemik bir enfeksiyon hastalığıdır. Herşeyi taklit eden bir kliniğe sahiptir.
3. Bruselloz kliniği nasıldır?
İnkübasyon süresi 1-3 hafta -3 ay kadardır. Tüm organ ve sistemleri tutabilir. Genellikle genel enfeksiyon belirtileri ile başlar. Başlangıç semptomları halsizlik, iştahsızlık, baş ağrısı, etraf ağrıları, sırt ağrısı, ateş ve terleme gibi genel enfeksiyon belirtileridir. Akut, subakut ve kronik brusellozda semptom süresi ve belirtiler değişebilmektedir.
4. Brusellozda tanı nasıl konmaktadır?
Anamnezde meslek, temas öyküsü, endemik bölgeye seyahat öyküsü, ateş ve ateşin seyri önemlidir. Tipik semptomları varlığı ( halsizlik, kilo kaybı, terleme, baş ağrısı, eklem ağrısı, bel ağrısı, karın ağrısı, bulantı kusma) düşünmek için önemlidir. Fizik muayene, ateş ve hepatosplenomegali varlığı anlamlıdır.
Biyokimyasal ve hematolojik tetkiklerde (lökopeni, lökositoz, normal lökosit, anemi, trombositopeni, pansitopeni, AST, ALT, bilirubin, CRP yüksekliği, ESR normal veya artmış olması gibi değişikliklerin saptanması yardımcıdır. Doku ve organların histopatolojik incelemesi (Lenfosit, histiosit ve dev hücre infiltrasyonları ile karakterize kronik inflamasyon, granülom, nekroz, apse formasyonu, vaskülit vb.) anlamlıdır. Görüntüleme teknikleri (ultrason, ekokardiyografi, röntgen, kemik sintigrafisi, bilgisayarlı tomografi, manyetik rezonans) uygun hastalarda kullanılabilir.
Mikrobiyolojik tanı için; bakteriyolojik, serolojik ve moleküler tanı yöntemleri kullanılabilmektedir. Kesin tanı KÜLTÜR ile konulmaktadır. En sık kan kültürü alınır. Kemik iliği kültürü, kan kültüründen daha duyarlıdır. Özellikle kronik brusellozda daha değerlidir. Vücut sıvısı kültürleri (BOS, idrar, balgam, plevral sıvı, prostat sıvısı, sinovyal sıvı, apse aspiratı …) yapılabilir. Doku biyopsi kültürleri ( Kemik iliği, kalp kapakçığı, vejetasyon, testis, epididim, prostatik doku, böbrek, lenf bezi, karaciğer, kemik, fetal doku, uterus dokusu, deri, tonsil, parotis bezi, meme….)
TANI- Kültür
A. Casteneda’nın klasik bifazik kan kültürü tekniği kullanılabilir. Bu yöntemle tanı 27 gün sürebilir, fakat 6 günde tanıya giden çeşitli çalışmalarda vardır
B. Lizis santrifügasyon yöntemi (Kan kültürlerinde üremenin arttırılması için)
Santrifüjle bakteriler konsantre edilir. Kan hücrelerinin ozmotik lizisi ile hücre içi bakteriler açığa çıkarılır. Castenada yöntemine göre daha duyarlı ve kısa sürede sonuçlanan daha iyi bir seçenektir.
C. Otomatize kan kültür sistemleri
Günümüzde kullanılan yeni devamlı – monitorizasyon sistemleri (BACTEC 9000 serileri) ile lizis yöntemiylsantrifügasyondan daha kısa sürede tanı konabilmektedir. Daha yüksek duyarlılık oranına sahiptir.
Serolojik sonuçlar, klinik ve epidemiyolojik veriler ile birlikte yorumlanmalıdır.
Tarama testi olarak Rose Bengal kullanılmaktadır. Standart Tüp Aglütinasyon testi (SAT) ve ELISA tanıda sıklıkla kullanılan testlerdir. Rose Bengal testi sonuçları mutlaka standart aglütinasyon testi (SAT) (Wright) ile doğrulanmalıdır. Serokonversiyon (serum antikor titresinin 4 kat artması), SAT titre ≥ 1/160 aktif enfeksiyon göstergesidir. Komplike ve/veya kronik enfeksiyonu olan hastalar için en yararlı olan testler; 2 merkaptoetanol (2-ME) aglütinasyon testi ve İmmün yakalama aglütinasyon (Brucellacapt) testi olarak tespit edilmiştir.
5. Tedavinin amacı nedir? Hangi ilaçlar kullanılır?
Tedavinin amacı semptomları azaltmak yada ortadan kaldırmak, hastalık süresini kısaltmak, komplikasyon ve relaps oranını azaltmaktır. Tedavide kullanılan ilaçların hücre içi etkinliği olmalı, kombinasyona dikkat edilmeli ve süre konusunda hassas olunmalıdır. Üç metaanalizden elde edilen verilere göre Streptomisin içeren rejimlerde relaps oranı daha düşüktür.
- Doksisiklin 200 mg/gün + rifampisin 600 – 900 mg/gün (6 hf)
- Doksisiklin (6 hf) +streptomisin (2-3 hf) en etkili rejim (streptomisin yerine gentamisin de olabilir)
Tetrasiklinler gebelikte kontrendikedir. Gebelikte optimal tedavi belirsizdir. Rifampisin + TMP/SMX kullanılabilir. 36. haftadan sonra rifampin monoterapisi önerilir. Çocuklarda rifampisin, TMP-SMZ veya gentamisin içeren rejimler kullanılır.
Komplikasyonlarda tedavi en az 3 ay olmalıdır. Endokarditte, kapak replasmanı + antibiyoterapi önerilmekte olup optimal tedavi süresi ile ilgili kontrollü çalışmalar yoktur. Bazı otörler tedavi süresini 2 – 4 ay arasında bildirmektedirler. BOS’a iyi geçen 2 veya 3’lü antibiyotiklerle (rifampisin, doksisiklin, seftriakson, TMP/SMZ ve streptomisin gibi) tedavi edilmelidir.
Brusella spp. Üremesi olduğunda rutin duyarlılık testi yapılması zorunlu değildir. Brusella tedavisinde kullanılan çoğu geleneksel antibiyotik in-vitro olarak etkilidir ancak bakterisidal etkileri in-vivo olarak farklı olabilir. Streptomisin içeren rejimlerde tedaviye yanıt daha yüksek, relaps oranı daha düşüktür. Spondilodiskit ve nörobruselloz gibi komplikasyonlarda tedavi süresi daha uzun ve 3’lü kombinasyonlar önerilmektedir. Endokardit tedavisinde medikal ve cerrahi tedavi birlikte uygulanmalıdır.
6. Brusellozda kimler risk grubundadır?
Risk grupları; hayvancılık yapanlar, hayvan çiftliklerinde çalışanlar, veterinerler, kasaplar, mezbaha çalışanları, avcılar, yün ve deri ile uğraşanlar ve laboratuvarlarda çalışan sağlık personelleridir.
7. Brusellozda korunma yolları nelerdir?
İnsanlarda brusellozdan korunmak için aşı mevcut değildir. Korunma ve kontrol önlemlerinde hayvan sağlığına ve insan sağlığına yönelik önlemler ve faaliyetler için beşeri ve veteriner hekimliğin birlikte çalışması gerekmektedir. Hayvan vakalarının azaltılmasına yönelik kontrol ve eliminasyon programları yürütülmelidir. Hastalıktan korunmak için pastörize edilmiş veya iyice kaynatılmış sütten yapılan ürünler (peynir, krema, tereyağı, kaymak, dondurma gibi) tercih edilmelidir. Salamura peynirler en az 3 ay bekledikten sonra tüketilmelidir. Sık sık düşük ve ölü doğum yapan hayvanlar hemen bir veteriner hekime muayene ettirilmelidir. Atık yavrulara, yavru zarlarına çıplak elle dokunulmamalıdır. Hayvanlar mutlaka Bruselloza karşı aşılatılmalıdır.
8. Brusellozda komplikasyonlar nelerdir?
Brusella spp. insanlarda birçok farklı organ sistemini etkileyebilir. En sık komplikasyon, osteoartiküler tutulum formu olan sakroileit, spondilit ve periferik artrittir. Bruselloz hastalarının %2 – 77’sinde bu komplikasyonlar görülebilir. Sakroileit genç erişkinlerde önemli bir bulgudur, vakaların neredeyse %80’ininde tek taraflı tutulum olur. Periferik artrit genellikle diz, kalça ve ayak bileği gibi büyük eklem bölgelerinde görülür. Genitoüriner tutulum, fokal brusellozun ikinci en sık görülen şeklidir; vakaların %2-10’u arasında görülebilir. Erkeklerde orşit ve/veya epididimit en yaygın görülen tablodur; prostatit ve testis apsesi daha az görülür. Kadınlarda tubo-ovaryan apse, sistit, interstisyel nefrit, glomerülonefrit ve renal apseye neden olabilir. Bunların dışında nörolojik tutulum (menenjit, ensefalit), kardiyovasküler tutulum (endokardit, perikardit, miyokardit), göz, cilt ve kemik iliği tutulumu görülebilir.
9. Brusellozda ülkemizdeki son durum nedir?
Bruselloz ülkemizde endemik bir hastalıktır. En fazla Güneydoğu Anadolu ve Doğu Anadolu bölgelerinde görülmektedir. Türkiye Halk Sağlığı Genel Müdürlüğü, Zoonotik Vektörel Hastalıklar Dairesi Başkanlığı’nın istatistiklerine göre ülkemizdeki bruselloz olgu sayısı en son 2017 yılında 6457 olarak bildirilmiştir. Hayvan brusellozu konusunda ülkemizde ulaşılabilen son yayında ortalama sürü prevalansının 2012 yılından itibaren kitlesel aşılama programlarıyla %12.3’e düştüğü bildirilmiştir. Ülkemizde insan brusellozu insidansı, özellikle 2012’deki kitlesel hayvan aşılamaları sayesinde 2012’den 2015 yılına kadar düşüş göstermiş ancak 2016 yılından itibaren, muhtemelen hayvanlarda hastalığın kontrolünün yetersizliğinin bir sonucu olarak tekrar yükselmeye başlamış ve 2019’da insidansı 12.32 / 100 000 kişiye çıkmıştır.
10. Brusellozda bildirim sistemi nasıldır?
Bruselloz bildirimi mecburi; ancak, ihbarı gerekli olmayan bir hastalıktır. Bütün sağlık kuruluşlarından bildirim yapılması gereken Grup A hastalıktır. Bildirimler, İl Sağlık Müdürlüklerine olası vaka ve kesin vaka şeklinde, Sağlık Bakanlığı’na ise kesin vaka şeklinde olmaktadır.
Türkiye EKMUD
Kaynaklar
https://iris.who.int/bitstream/handle/10665/43597/WHO_CDS_EPR_2006.7_eng.pdf?sequence=1
https://www.who.int/publications/i/item/9789241547130
Centers for Disease Control (CDC) Brucellosis Reference Guide 2017. https://www.cdc.gov/brucellosis/pdf/brucellosi-reference-guide.pdf (Accessed on May 23, 2019).
Solís García del Pozo J, et al. PLoS One 2012; 7:e32090. Skalsky K et al. BMJ 2008; 336:701. Ariza J et al,. Ann Intern Med 1992; 117:25.
Ozsoyler I ve ark. Prog Cardiovasc Dis 2005
Doganay M, Aygen B. Human brucellosis: An overview. Int J Infect Dis 2003; 7:173.
Bruselloz İstatistik Verileri [Internet]. Ankara: T.C Sağlık Bakanlığı Halk Sağlığı Genel Müdürlüğü Zoonotik ve Vektörel Hastalıklar Daire Başkanlığı. [erişim 27 Mart 2024]. https://hsgm.saglik.gov.tr/tr/zoonotikvektorel-bruselloz/istatistik.html
Çakır Ş, Yıldırım M. [Control and eradication strategies of brucellosis small ruminants in Turkey]. Dicle Üniv Vet Fak Derg. 2018;(2)98-104. Turkish.
Inan A, Erdem H, Elaldi N, et al. Brucellosis in pregnancy: results of multicenter ID-IRI study. Eur J Clin Microbiol Infect Dis 2019; 38:1261.
Erdem H, Ulu-Kilic A, Kilic S, et al. Efficacy and tolerability of antibiotic combinations in neurobrucellosis: results of the Istanbul study. Antimicrob Agents Chemother 2012; 56:1523.